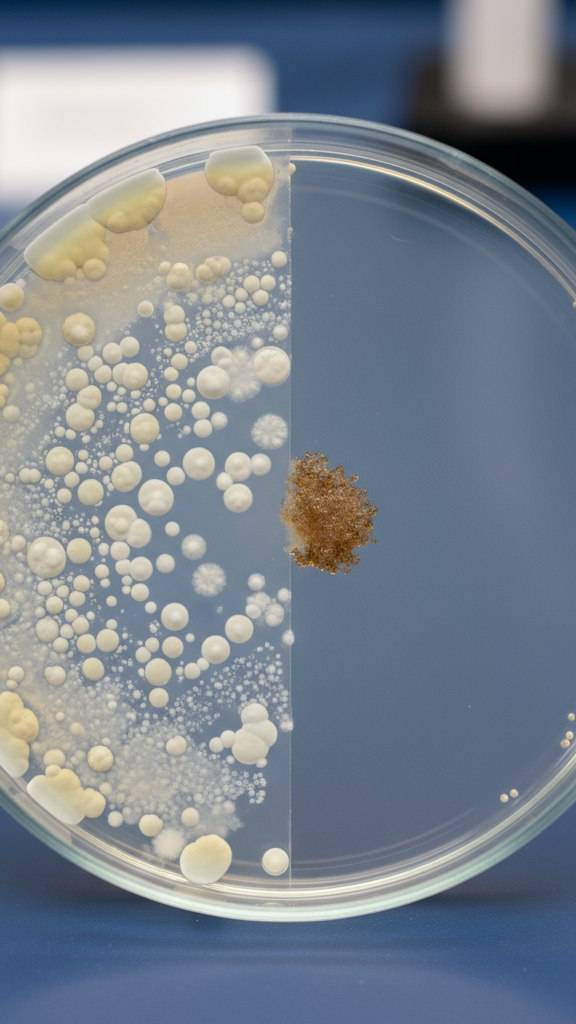

Удивительная промышленная техника на совершенно новом уровне - видео
Patreon
Промышленность в разных ее проявлениях требует задействования всевозможной техники: от малогабаритных но суперпрочных домкратов до настоящих гигантов среди комбайнов в десятки раз превышающих как человеческий рост так и возможности. Позвольте представить Вам подборку удивительной промышленной техники на совершенно новом уровне поражающей своим функционалом.
Какое изобретение понравилось Вам больше всего? Напишите в комментариях.
Удивительная промышленная техника на совершенно новом...
Источник видео: RuTube.ru (Разное)

Эгине, у вас хорошее чувство юмора, очень приятно вас смотреть, все время улыбаюсь, так держать
я хачу скачать читы на когаму но незнаю?
Интересный канал!
Спасибо!
Очень интересный сюжет, особенно когда смотришь про свой родной город и понимаешь сколько ему пришлось пережить. Спасибо автору что не даёте нам об этом забыть.